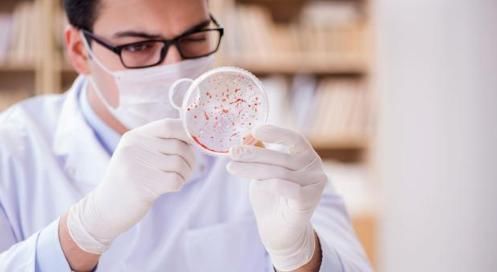
胃肠道|感染幽门螺旋杆菌怎么办谨记3吃4不做,有助胃肠道健康

文章插图
4. 不做传播幽门螺杆菌的危险行为:幽门螺杆菌之所以传播的这么广泛,主要还是与它的传播途径由有关,实际上我们在日常生活中,幽门螺杆菌的传播主要是通过口口传播,和粪口传播两种途径来引起相互感染的,因此,对于幽门螺杆菌感染者来说,应该避免口对口喂食,口对口接吻等行为,这些行为都会造成幽门螺杆菌的口口传播,在家人或朋友之间共餐时也要注意,使用公筷等方式,可以有效的减少幽门螺杆菌的口口传播。另外,在日常生活中养成良好的卫生习惯,饭前便后要洗手,多注意卫生,也是减少幽门螺杆菌粪口传播的重要方面。之所以强调这些方面,一方面是避免幽门螺杆菌感染者进一步把这个致病菌传给他人,另一方面也是为了避免幽门螺杆菌的交叉重复感染。
说了这么多,对于幽门螺杆菌感染者来说,如果已经出现了确实需要根治的适应症或相关问题,那么最好是遵医嘱进行正规的用药根除治疗,而对于无症状的幽门螺杆菌感染者,与其整日担心,或者相信某些偏方,真的不如做到上述几个方面来得更靠谱,更重要。
推荐阅读
- 身体出现这6种异常变化,是胃肠道疾病的信号,赶快上医院检查
- 检测|幽门螺旋杆菌检测呈阳性,会得胃癌吗?
- 肝吸虫、肺吸虫…感染的孩子才1岁!这个坏习惯很多家庭都有
- 肝吸虫、肺吸虫…感染的孩子才1岁!警惕!这个坏习惯很多家庭都有
- 警惕!1岁男童感染肝吸虫,这个坏习惯很多家庭都有
- 尖锐湿疣|【关注】除了宫颈癌,感染HPV还会导致这种疾病
- 幽门螺杆菌会引发胃癌?听听松江消化内科医师怎么说
- 通淋|锅巴菜,见过吗?利尿通淋,清热解毒。治尿路感染和结石
- Hp治疗再添一员猛将,调节肠道菌群,还是得要益生菌来
- 新冠|视频|能够预防新冠病毒感染的香囊





![[儿科医生鲍秀兰]而你却在卖力敲螃蟹,小朋友你是否有很多问号:你的家人在吃螃蟹](https://imgcdn.toutiaoyule.com/20200327/20200327084558277487a_t.jpeg)











